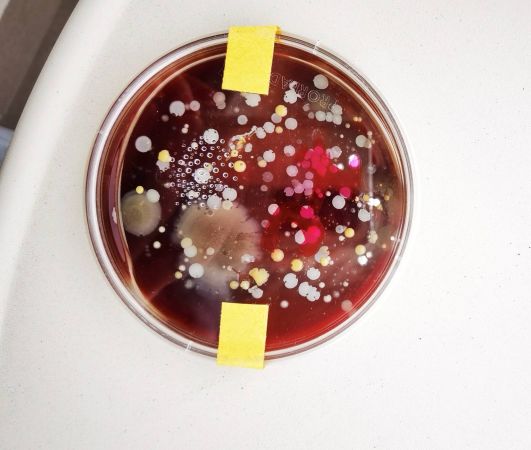
IMG ed511d058e377030dec27f464099d537 V

Students love playing with microorganism as it is always fun, but precaution measures have to be taken.
We learned about the use of antiseptic technics and tried to grow "good" probiotic bacteria on agar jelly. The results were amazing. Look at our pretty agar canvases.